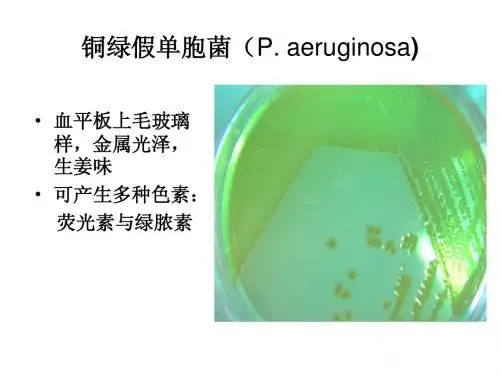

铜绿假单胞菌噬菌体PaP2 的结构蛋白及其
- 格式:pdf
- 大小:150.26 KB
- 文档页数:4




铜绿假单胞菌含Pilz结构域蛋白基因的克隆及原核表达【摘要】目的克隆铜绿假单胞菌含Pilz结构域蛋白基因并构建其原核表达载体,为进一步研究这七种含Pilz结构域蛋白是否为第二信使c-di-GMP 潜在的受体分子奠定实验基础。
方法提取铜绿假单胞菌PAO1基因组DNA, 用PCR方法从中扩增出七种功能未知的含Pilz 结构域蛋白基因, 将其克隆到原核表达载体pET32a中, 在大肠杆菌BL21(DE3)中用IPTG诱导表达,表达产物通过十二烷基磺酸钠-聚丙烯酰胺凝胶电泳(SDS-PAGE)进行鉴定。
结果成功扩增出七种含Pilz 结构域蛋白基因并构建其原核表达载体, 测序结果与NCBI数据库收录序列相一致。
SDS-PAGE检验证明目的基因在大肠杆菌BL21中获得高效表达。
结论从铜绿假单胞菌基因组中成功地克隆了七种含Pilz 结构域蛋白基因,其构建的原核表达载体在大肠杆菌BL21中获得了高效表达。
【关键词】铜绿假单胞菌;c-di-GMP第二信使;Pilz结构域蛋白;基因克隆;原核表达载体构建铜绿假单胞菌( Pseudomonas aeruginosa ), 又称绿脓杆菌, 是临床感染性疾病中常见的条件致病菌之一。
该菌致病机制复杂而多样, 其固有的对抗生素和消毒剂的耐受性使治疗十分困难。
铜绿假单胞菌全基因组测序的完成[1], 特别是近几年环鸟苷二磷酸(c-di-GMP)对细菌生物学功能调控作用的突破性研究进展, 使得我们在分子水平上深入探讨其耐药机理, 在信号途径的研究中寻找新的作用靶点成为了可能。
作为一种广泛存在于细菌中的新型的第二信使, c-di-GMP 参与调控了多种细菌生物学功能,如细菌的运动性、生物膜合成、细菌毒性及细菌的群体感应等[2],但其作用机制尚不完全清楚。
铜绿假单胞菌全基因组共有5,670个基因, 利用生物信息学手段,在其全基因组中发现了八种编码Pilz结构域(Pfam07238)蛋白基因。

铜绿假单胞菌下呼吸道感染诊治专家共识2014-02-12 18:18来源:中华结核和呼吸杂志中华医学会呼吸病学分会感染学组字体大小:铜绿假单胞菌〔Pseudomonasaeruginosa’P.aeruginosa’PA>是一种革兰阴性杆菌,也是临床,常见的非发酵菌,在自然界广泛分布,可作为正常菌群在体皮肤外表别离到’还可污染医疗器械甚至消毒液,从而导致医源性感染,是医院获得性感染重要的条件致病菌,具有易定植、易变异和多耐药的特点.下呼吸道是医院内细菌感染最常见的发生部位,感染种类主要包括支气管扩X合并感染、慢性阻塞性肺疾病〔简称慢阻肺〕合并感染和肺炎等,由多重耐药PA<multidrugresistantPaeruginosa,MDR-PA>引起的下呼吸道感染病死率髙,治疗困难,因此规XPA下呼吸道感染的诊断和治疗具有特别重要的意义.一、微生物学特点假单胞菌属为需氧、有鞭毛、无芽孢与无荚膜的革兰阴性杆菌和不动杆菌属、黄杆菌属、嗜麦芽窄食单胞菌与洋葱伯克霍尔德菌等共同构成非发酵糖革兰阴性杆菌,是常见的条件致病菌,尤其是医院感染的主要病原之一.μmμm,一端有单鞭毛,无芽孢,成双或短链排列.PA能产生多种色素,如绿脓素和荧光素等,专性需氧,局部菌株能在兼性厌氧条件下生长.二、流行病学<一>流行状况近年来,PA感染的流行病学特点突出地表现在两个方面,一是院内感染,尤其是肺部感染的发病率不断增加.国内已有多项大型流行病学调查显示我国PA感染的严重性,其中最具代表性的"中国CHINET细菌耐药性监测〞资料显示,2012年综合性教学医院PA的别离率占所有别离菌的第5位,2005—2012年PA的别离率分别占革兰阴性菌的6%,14.1.%、16.9%、16.4%、15.8%、14.8%、14.2%和14.0%,居第2~5位《3b有13家教学医院参与的中国医院院内获得性细菌耐药性分析〔CARES>结果示,2009年和2011年PA在所有别离细菌中也是居第4位,别离率分别为10.8%和12.6%,且MDR-PA的比例高达12.7%.这一点在呼吸系统感染更为突出,美国疾病预防控制中心〔CDC>的全国医院感染研究数据显示,PA肺炎的发生率在逐年升高,1975—2003年医院获得性肺炎〔HAP〕中PA比例从9.6%上升至18.1%,几乎翻了I倍.—项大规模ICU感染病原学的流行病学调查结果显示,PA是最常见的革兰阴性需氧菌,占23%<8244/35790>,也是最常见的从呼吸道别离出的细菌<31.6%>.美国一项关于呼吸机相关性肺炎〔VAP>的回顾性研究结果显示,PA别离率达9.3%e即便得到有效的治疗,PA导致的感染总病死率仍高达42.1%~87.0%,直接病死率为32.0%~42.8%.2005年胡必杰等报道562例HAP中PA的别离率为18.6%,列第I位;我国近期进展的13家大型教学医院HAP的临床调查结果显示,PA的别离率为20.9%,居第2位.2011年CARES 研究也证实HAP中PA的别离率为11.9%,居第2位.二是PA的耐药率居高不下,全球细菌耐药监测数据〔SENTRY>显示,PA在HAP致病原中居前几位,同时对常用抗菌药物的耐药率逐年升髙.中国CHlNET2005-2012年连续监测资料显示,PA对常用抗菌药物的耐药率保持在较高水平,但略呈下降趋势.如亚胺培南的年度耐药率分别为31.0%、42.8%、35.8%、30.5%、30.5%、8%、29.1%和29.1%,对美罗培南的年度耐药率分别为32.0%、34.1%,28.5%,24.5%,25.2%、25.8%,25.0%和27.1%,但其中全耐药<PDR>菌株数量显著增多,在2011年和2012年分别达到I.8%和1.5%.2011年CARES研究也证实PA对亚胺培南和美罗培南的耐药率达29.3%和22.1%,这一点在呼吸系统感染中更为突出,我国HAP临床调查结果显示,PA对亚胺培南和美罗培南的耐药率分别高达70.7%和48.8%,远高于CHINET监测中各种标本别离菌中PA对碳青霉烯类的耐药率.PA对于其他具有抗假单胞菌活性的药物敏感度也不容乐观,2012年的中国CHINET资料显示PA对阿米卡星、头孢哌酮-舒巴坦、头孢他啶、环丙沙星和哌拉西林-他唑巴坦的耐药率分别为13.5%、19.8%、19.6%,17.9%和17.5%.PA导致的社区获得性肺炎〔CAP>非常少见,在美国CAP中PA的别离率仅有0.9%~I.9%,中国的流行病学调查结果类似,只有1.0%.一项包括127项研究、涉与33148例患者的荟萃分析结果提示,由PA引起的CAP患者只有18例,但是总病死率高达61.1%<11/18>.说明需要人住ICU、有结构性肺病变的CAP中PA也是不可无视的致病原.结构性肺病变如支气管扩X症、慢阻肺、肺囊性纤维化患者是PA感染的高发人群,研究结果显示,3%~20%的稳定期慢阻肺患者下呼吸道痰标本和经支气管镜吸引标本的PA培养阳性,而且定植的频率随着气流阻塞的加重而增加;采用经支气管镜保护性毛刷采集的标本,在防止了呼吸道污染的情况下,仍有3%~10%的慢阻肺急性加重患者的下呼吸道标本中可别离到PA.<二>耐药机制定义:一般认为多重耐药〔MDR>是指细菌对于常见抗菌药物〔包括头孢菌素类、碳青霉烯类、β-内酰胺酶抑制剂复合制剂、氟喹诺酮类和氨基糖苷类〕中3类或3类以上的药物耐药,广泛耐药<XDR>是指细菌仅对I~2种抗菌药物敏感〔通常指黏菌素和替加环素〕,而PDR 如此是指对目前所有临床应用的有代表性的各类抗菌药物均耐药的菌株.PA是临床最常见的MDR和PDR致病菌之其耐药机制涉与多个方面:<1>产生灭活酶:PA可产生β-内酰胺酶、氨基糖苷类修饰酶、氯霉素乙酰转移酶等,其中β-内酰胺酶是耐药的主要机制,具有重要的临床价值,主要包括C类头孢菌素酶<AmpC>、超广谱β-内酰胺酶〔ESBL>、金属酶〔MBL>和肺炎克雷伯菌产的碳青霉烯酶〔KPC>等.<2>膜通透性下降:①主动外排系统过度表达:PA细胞膜上的许多蛋白具有将抗菌药物主动外排到细胞外的作用,并与细胞外膜的低通透性共同对耐药起协同作用,在致PA多重耐药中发挥越来越重要的作用.在PA细胞膜上常见的7种外排系统包括MexAB-oprM、MexXY-oprM、MexCD-oprJ、MexEF-oprN,MexJk-oprM,MexGHI-opmD和MexVW-oprM 等.外排系统能有效去除除多黏菌素外的所有抗菌药物,从而导致MDR.②膜孔蛋白丢失或表达下降:中国碳青霉烯耐药PA的主要耐药机制是外膜孔蛋白0PrD2缺失与表达量下降,导致药物难以进人细菌细胞内.〔3〕靶位改变:①拓扑异构酶突变:氟喹诺酮类抗菌药物的作用靶位是细菌DNA拓扑异构酶II和拓扑异构酶IV.PA对喹诺酮类药物耐药主要是由于编码两类拓扑异构酶的基因突变,导致酶结构改变,使药物不能与酶-DNA复合物稳定结合而失去抗菌效力.②16s核糖体RNA 甲基酶是氨基糖苷类抗菌药物耐药的原因之一.〔4〕细菌生物被膜〔bacterialbiofilm>形成:生物被膜是指细菌附着于惰性物体外表后,繁殖并分泌一些多糖基质和纤维蛋白等复合物,将细菌粘连包裹其中而形成的膜样物.细菌能够通过生物被膜的形式生存,逃避机体免疫和抗菌药物的杀伤作用.密度感知系统〔quorumsensing,QS>的细胞沟通机制在革兰阴性杆菌,特别是PA的生物被膜形成中发挥重要作用.目前巳经知道PA的QS效应机制主要通过2个信号系统〔LasI-LasR 和RhII-RhIR>构成的级联反响来实现调控.生物被膜相关感染包括生物医学材料相关感染〔如导管插管相关感染等〕和细菌生物被膜病〔如弥漫性泛细支气管炎等〕,常呈慢性过程,反复发作,难以治愈《目前比拟认可的是14元环和15元环大环内酯类抗生素,虽然其自身没有对抗PA的作用,但能抑制生物被膜的形成,同时具有调节免疫与增强吞噬细胞的吞噬作用,其中红霉素、克拉霉素、阿奇霉素和罗红霉素均可有效抑制生物被膜的形成,可与抗PA药物联合应用治疗PA生物被膜相关感染.16元环大环内酯类抗生素如麦迪霉素、交沙霉素、乙酰螺旋霉素等对生物被膜形成无效.除14元环、15元环大环内酯类外,喹诺酮类也有一定的抑制细菌生物被膜形成的作用.<5>其他耐药机制:整合子〔integron>是存在于细菌质粒、染色体或转座子上的一种基因捕获和表达的遗传单位,可以通过接合、转化、转导和转座等方法在细菌间转移,成为细菌MDR 迅速开展的重要原因,这种情况在革兰阴性菌尤其是PA中更为显著.近些年对于整合子的研究日趋增多,整合子检出率呈逐年上升趋势,由2006年的37.5%上升至2008年的52.4%.值得注意的是,2012年CHINET细菌耐药性检测结果显示,PA对碳青霉烯类的耐药率巳经高于青霉素类和头孢菌素类抗生素,其机制尚需要进一步探讨,应引起临床医生的高度重视. 三、珍断由于PA在呼吸道的定植极为常见,目前临床上对PA所致下呼吸道感染的最大困惑是诊断问题,即痰或者经气管吸引标本别离到的PA应该如何区别是定植菌还是感染菌?区别定植与感染对于抗菌药物的合理使用非常重要,否如此极易导致治疗不足或治疗过度,但这恰恰是呼吸道感染临床迄今仍难以解决的问题.<一>PA感染的危险因素PA下呼吸道感染患者多有危险因素,常见的包括:〔1〕皮肤黏膜屏障发生破坏,如气管插管、机械通气、严重烧伤、留置中心静脉导管或胃管;〔2〕免疫功能低下,如中性粒细胞缺乏、实体肿瘤放化疗、糖皮质激素治疗与获得性免疫缺陷综合征<AIDS>;〔3〕慢性结构性肺病,如支气管扩X症、慢阻肺、肺囊性纤维化;〔4〕长期住院,尤其是长期住ICU;〔5〕曾经长期使用第三代头孢菌素、碳青霉烯类或者含酶抑制剂青霉素等抗菌药物,致菌群失调.当患者存在这些危险因素时,如再与已感染PA的患者处于同一病房,或工作人员疏于环境和手部清洁,或不合理使用抗菌药物等,如此发生PA,甚至MDR-PA下呼吸道感染的机会更多.在呼吸系统疾病中,慢阻肺是最常见的容易发生PA感染的根底疾病之一,尤其是进展期以与因病情加重需要住ICU和机械通气的患者s当慢阻肺急性加重患者出现以下4项中的2项时应考虑PA感染的可能:〔1〕近期住院史;〔2〕有经常〔>4个疗程/年〕或近期〔近3个月内〕抗菌药物应用史;〔3〕病情严重〔FEV1<30%>;<4>应用口服糖皮质激素〔近2周服用泼尼松龙>10mg/d>.<二.>PA感染的临床表现PA为条件致病菌,常在患者体内或者医院环境中寄植,感染多继发于免疫功能低下的患者.因此,当这些患者出现发热、咳嗽、咳黄色或黄绿色脓性痰、痰液黏稠且伴有气急等呼吸道症状时,应考虑PA感染的可能;尤其是原有肺部慢性疾病的患者,平时常伴慢性咳嗽、咳痰,当出现黄绿色脓痰、呼吸困难加重与肺功能进展性减退时,应考虑PA感染的可能.HAP患者,尤其是VAP患者PA是最常见的致病菌之一,这与气管插管或者切开建立人工气道后PA能够直接侵人下呼吸道,引起吸人性感染有关.PA下呼吸道感染的影像学无特异性,可表现为弥漫性支气管肺炎,伴有小结节和小的透亮区"微脓肿〞<其病理改变根底类似体表感染,为特征性坏疽性深脓疱,周围有红斑环绕〕.PA菌血症多继发于大面积烧伤、静脉导管、心瓣膜置换术与各种严重慢性疾病等的过程中,病死率高,可有高热,常伴休克、急性呼吸窘迫综合征<ARDS>或弥散性血管内凝血〔DIC>等.在严重全身感染时炎症标志物,如内毒素和降钙素原〔PCT>可以出现升高.PA下呼吸道感染可以分为I种类型:〔1〕慢性气道疾病合并PA感染;〔2〕吸人性肺炎〔社区获得性或医院获得性〕;〔3〕血源性PA肺炎.值得注意的是,在临床怀疑PA下呼吸道感染引起的体温升高时,需排除其他感染如鼻窦炎、尿路感染或导管相关感染等导致的发热.<三>如何区别定植与感染PA-HAP很少血培养阳性,所以难以通过血培养确定病原学诊断,判断感染与否的证据主要来自呼吸道标本,而PA在结构性肺病变患者呼吸道存在较高的定植率,因此,临床上面临的一个难题是如何区别培养阳性的PA是定植还是感染.从气管插管后气道内分泌物中能够在很长时间内持续培养出PA,但可以没有症状、体征和相应的肺部影像学表现,即使是脓性痰或者气管内分泌物PA培养阳性亦不能诊断VAP.文献报道,4%~15%的慢阻肺患者痰中能够别离到PA.广谱抗菌药物的使用能增加ICU患者气道中PA的定植,这是由于PA能增加黏液的分泌,破坏纤毛的活力,引起上皮结构受损,影响肺的去除能力.但与血培养中别离的PA相比,气道寄植的PA虽然毒力较弱,但耐药性更强,更易产生生物被膜.即使经过有效地抗菌药物治疗,PA 仍可从VAP发生后8d的下呼吸道别离到.因此,呼吸道分泌物,包括痰、咽拭子、气管吸引标本、保护性毛刷采集的标本与BALF等PA 培养阳性,必须慎重评估其临床意义.就目前的认知水平,可从以下几个方面着手解决PA定植与感染的鉴别诊断问题.首先,临床医师采集呼吸道标本时,应严格掌握痰标本的正确留取方法,如对患者进展充分培训,留取深部咳出的痰液,并尽量防止上呼吸道分泌物的污染;气管吸引标本、保护性毛刷标本和BALF标本要比痰标本更可靠、更有价值,应尽可能采用,以提高呼吸道分泌物标本的质量.临床微生物实验室要严格把握痰标本的质量,痰标本接种前应进展革兰染色镜检,判断痰标本是否合格,同时注意有无白细胞吞噬或伴行现象与细菌的染色和形态.痰培养应尽量采用定量培养,至少应做半定量培养.呼吸道标本的半定量、定量细菌培养能够为临床提供有帮助的参考价值.细菌定量培养结果气管内吸引物<PA≥105CFU/ml>、BALF〔PA≥104CFU/ml>、防污染保护性气管镜毛刷采集的标本〔PA≥104CFU/ml〕达到上述阈值时,有更大的参考意义.当呼吸道标本PA培养阳性时,应结合临床情况进展仔细分析.首先患者是否存在肺部感染的临床与实验室表现,是否有PA感染的危险因素,如果患者一般情况良好,又没有危险因素,PA 培养阳性多考虑为污染或定植,可以观察,暂不做抗感染处理,更多地采取感染控制措施.但如果患者存在高危因素或已有下呼吸道感染的临床表现,应高度警惕PA感染的可能,再充分参考其他临床指标如痰涂片镜检和定量、半定量培养结果,C反响蛋白和降钙素原等综合判断.患者在出现下呼吸道感染时第一次呼吸道标本PA培养阳性的临床意义较大,应结合临床危险因素进展分析是否为感染致病菌;而在初始治疗采用不针对非发酵菌的抗菌药物治疗过程中,治疗有效又反复培养出PA,如此应考虑为抗菌药物筛选的结果.临床另一困难之处是在那些具有PA感染危险因素的患者,呼吸道分泌物PA与其他病原体同时培养阳性时责任菌的判断,需要慎重确定..未经治疗患者如果与常见对抗菌药物敏感的致病菌如肺炎克雷伯菌、肠杆菌属细菌等同时培养阳性,如此PA为定植菌的可能性大;如果与MDR菌如耐甲氧西林的金黄色葡萄球菌<MRSA>、鲍曼不动杆菌等同时培养阳性,前者又占优势,如此需要分析各自定量和半定量培养结果,如果PA为低浓度培养阳性如此定植菌的可能性大.总之,与其他非发酵菌一样,在痰标本中别离出PA的临床意义即使想尽方法仍很难正确评价.本共识建议临床与微生物专家互通信息,共同协作解决这一问题,但最终判定责任归于临床而非微生物科.有无感染的临床表现最为重要,即使是合格痰标本别离到多量单-PA,但临床并不存在任何下呼吸道感染的表现,也无需针对PA治疗.如果同时别离到其他细菌,又有下呼吸道感染的临床表现,如此需要区别何种是真正的致病原或为混合感染.当针对单一PA治疗后疗效满意时较易确定是PA感染,但当疗效不满意时也难以完全否认,因为尚有剂量、疗程、联合用药与否、是否有混合感染〔特别是厌氧菌〕等许多问题的干扰,也可能在治疗过程中产生急性耐药〔以单药治疗最为常见〕.因此,在呼吸道标本别离到PA的患者是否需要抗菌药物治疗应当参考以下几点:〔1〕有与下呼吸道感染相符合的临床症状、体征和影像学上出现新的、或持续的、或加重的肺部渗出、浸润、实变;〔2〕宿主因素,如根底疾病、免疫状态、先期抗菌药物治疗、其他与发病相关的危险因素如机械通气与否与时间等;〔3〕正在承受非抗PA抗菌药物治疗的患者如果病情一度好转,复又加重,在时间上与PA的出现相符合,并排除其他因素引起的病情加重;〔4〕从标本采集方法、标本质量、细菌浓度〔定量或半定量培养〕、涂片所见等,综合评价阳性培养结果的临床意义,如痰培养屡次提示PA优势生长如此具有较大的临床意义.一旦决定针对PA进展治疗后,应在72h内评价疗效,判定是否继续原治疗方案.四、治疗由于细菌耐药性的不断增加,临床上对PA下呼吸道感染的治疗面临越来越多的困难.常应用于PA感染治疗的药物包括抗假单胞菌青霉素和头孢菌素、氨曲南、氨基糖苷类、氟喹诺酮类与碳青霉烯类等,特别是碳青霉烯类敏感度均有所降低.近年来在大型综合医院内由于PA对碳青霉烯类耐药性迅速增加,且同时对其他多种抗菌药物耐药,导致XDR甚至PDR菌株不断增多,使可应用的敏感药物非常有限,治疗困难.<一〕PA下呼吸道感染的治疗原如此PA下呼吸道感染的治疗应该遵循以下原如此:〔1〕选择有抗PA活性的抗菌药物,通常需要联合治疗;〔2〕根据药代动力学〔PK>/药效学<PD>理论选择正确的给药剂量和用药方式;〔3〕充分的疗程;〔4〕消除危险因素;〔5〕重视抗感染外的综合治疗.<二>具有抗PA活性的抗菌药物〔表I>抗PA青霉素类与其与β-内酰胺酶抑制剂复合制剂:包括替卡西林、羧苄西林、哌拉西林、美洛西林、阿洛西林、哌拉西林/他唑巴坦、替卡西林/克拉维酸,其中最具代表性的药物是哌拉西林/他唑巴坦.2012年CHINET细菌耐药性检测结果显示,PA对哌拉西林/他唑巴坦的敏感度为68.4%,高于单药哌拉西林<62.6%>,而替卡西林/克拉维酸的敏感度仅为19.7%.即使在HAP中PA对哌拉西林/他唑巴坦的敏感度同样可达78.0%<而单药哌拉西林为67.1%>,显示了良好的抗PA活性,是治疗PA感染的根底用药之一.抗PA头孢菌素类与其与β-内酰胺酶抑制剂复合制剂:2012年CHINET细菌耐药性检测结果显示,PA对头孢他啶、头孢哌酮、头孢吡肟、头孢哌酮/舒巴坦的敏感度分别为74.0%,49.6%、71.7%和62.5%.抗假单胞菌碳青霉烯类:包括美罗培南、亚胺培南;帕尼培南和比阿培南.2012年CHINET 各种标本别离细菌耐药性检测结果显示,PA对亚胺培南、美罗培南的敏感度分别为66.6%和67.7%,但在教学医院HAP患者痰中别离到的PA对这两种药物的敏感度只有30%左右.对PA引起的严重感染,美罗培南的常用剂量为Ig,1次/6~8h,最好能使用静脉泵给药,每次静脉滴注时间持续3h.亚胺培南的常用剂量为Ig,1次/6~8h,使用静脉泵给药,每次持续2h.其他如帕尼培南,常用剂量为0.5g,1次/6~8h,或Ig,1次/12h;比阿培南的常用剂量为0.3g,1次/6h,或6g,1次/12h.需要注意的是,厄他培南对PA无抗菌活性.国内目前还有法罗培南供给,属青霉烯类而非碳青霉烯类,但为口服制剂,很少用于PA感染的治疗.噻肟单酰胺菌素类:2012年CHINET细菌耐药性检测结果显示,PA对氨曲南的敏感度为49.9,可试用于对青霉素与头孢菌素过敏者以与产金属酶的革兰阴性菌感染者,但氨曲南一般不单独用于抗PA感染,应联合其他抗PA的有效药物,可以发挥协同作用.抗PA喹诺酮类:此类药物中环丙沙星和左氧沙星都具有较强的抗PA活性,但环丙沙星的抗PA活性更强,MIC值为0.5mg/L,低于左氧沙星〔I.0mg/L>;左氧沙星的抗菌活性与环丙沙星相仿,其口服吸收率高,肺组织浓度高,但左氧沙星通常不用于PA的肺外感染.2012年CHINET细菌耐药性检测结果显示,PA对环丙沙星和左氧沙星的敏感度分别为75.2%和72.5%.此类药物为浓度依赖性抗生素,半衰期较长者多主X1次/d给药,如左氧沙星0.5~0.75g,静脉滴注,1次/d;欧洲建议重症感染可用到0.5g,静脉滴注,1次/12h.环丙沙星由于半衰期较短,同时日剂量单次给药会明显增加不良反响,故依然采用日剂量分次给药.氨基糖苷类:常用的有阿米卡星、庆大霉素和妥布霉素,应用于临床的还有异帕米星、奈替米星、依替米星,其中以阿米卡星的活性最强.2012年CHINET细菌耐药性检测结果显示,PA对阿米卡星和庆大霉素的敏感度分别为82.3%和71.3%.此类药物通常不单独应用于肺部感染.根据PK/PD理论,此类药物的药效为浓度依赖性,且耳肾的毒性反响并不依赖于血药浓度,主X无论半衰期长短都将过去常用的2次/d或屡次给药方法改为日剂量单次给药.但国内外的推荐剂量之间有差异,国内通常推荐剂量阿米卡星为15mg·kg-1d-1静脉滴注,1次/d;妥布霉素和庆大霉素为7mg·kg-1d-1,静脉滴注,1次/d;我国常用的还有异帕米星、奈替米星和依替米星.阿米卡星欧洲推荐的剂量为15~20mg·kg-1d-1,ATS推荐的剂量为20mg·kg-1d-1,高于我国的推荐剂量,这值得引起我国临床医生的注意,提示我国在临床实践中可能存在治疗剂量不足的情况;另外,欧美推荐的剂量是否适合我国人群,其安全性尚需要我国高等级循证医学证据来支持.为减少不良反响的发生,此类药物建议疗程通常不超过I周.多黏菌素:包括多黏菌素B、多黏菌素E<colistin,黏菌素〕,主要应用于XDR-PA菌株,或联合治疗应用于PDR-PA菌株感染.2012年CHINET细菌耐药性检测结果显示,PA对多黏菌素B的敏感度为99.0%,此类药物的肾毒性明显,剂量选择必须根据肌酐去除率调整临床上主要应用的是多黏菌素E.该类药物存在一定的异质性耐药,常需联合应用其他抗菌药物,可与抗PA碳青霉烯类或氨基糖苷类、喹诺酮类、抗PA其他β-内酰胺类联合使用.在一项VAP的对照研究中,静脉滴注多黏菌素的临床有效率达75%,与对照组亚胺培南的72%相似.磷霉素:磷霉素通过与细菌催化肽聚糖合成的磷酸烯醇转移酶不可逆结合来抑制细菌细胞壁合成,从而起到杀菌作用.2012年CHINET细菌耐药性检测结果显示,PA对磷霉素的敏感度为53.6%.磷霉素对包括PA在内的多种致病菌均有较弱的抗菌活性,该药消除半衰期T1/2P平均为5.7h.磷霉素钠注射剂可与其他抗菌药物联合应用,治疗由敏感PA所致中、重症感染,如血流感染、腹膜炎、呼吸道感染、泌尿系感染与骨髓炎等,但一般不单独应用.<三>抗菌药物的合理使用1.抗菌药物的选择:对于别离菌为非MDR-PA的较轻症下呼吸道感染患者,没有明显根底疾病,可以采用上述畢有抗假单胞菌活性的抗菌药物单药治疗,通常采用抗PAβ-内酰胺类抗生素,如酶抑制剂复合制剂〔哌拉西林/他唑巴坦、头孢哌酮/舒巴坦〕、头孢菌素类〔头孢他啶、头孢吡肟〕和碳青霉烯类〔美罗培南、亚胺培南〕,经静脉给药,并给予充分的剂量.氟喹诺酮类和氨基糖苷类可在β-内酰胺类过敏或其他原因不能使用时采用,或作为联合治疗用药.对于别离菌为非MDR-PA但有根底疾病或存在PA感染危险因素的下呼吸道感染患者,需要根据其具体情况决定.通常轻症患者也可以采用单药治疗,但应防止选择近期内患者曾经使用过的药物;而重症患者常需要联合治疗.对耐药PA感染患者的初始治疗应采用联合治疗.联合治疗:主要用于MDR-PA下呼吸道感染患者.体外抗菌研究结果显示,某些联合治疗方案存在不同程度的协同作用,如青霉烯类〔亚胺培南〕联合阿米卡星或异帕米星体外抗MDR-PA 时4.0%呈现协同作用,46.0%呈现局部协同作用,临床研究结果也证实多药联合治疗可降低PA肺部感染患者的病死率.包含5个临床研究的荟萃分析结果显示,比拟单药与多药联合治疗PA感染的疗效,联合用药组的病死率较单药治疗组低10%~20%.β-内酰胺类抗生素与氨基糖苷类或氟喹诺酮类抗菌药物联合后均可提高对PA的抗菌活性,但氨基糖苷类对β-内酰胺类抗生素的增效作用略强于氟喹诺酮类.所以,PA肺炎治疗的国内外指南〔无论2007年的IDSA还是2005年ATS指南>均推荐联合用药,包括抗PAβ-内酰胺类+氨基糖苷类,或抗PAβ-内酷胺类+抗PA喹诺酮类,或抗PA的喹诺酮类+氨基糖苷类;也可采用双β-内酰胺类药物治疗,如哌拉西林/他唑巴坦+氨曲南.而对碳青霉烯类耐药尤其是PDR-PA肺部感染,国外推荐在上述联合的根底上再加多黏菌素. 14元环与15元环大环内酯类药物与抗PA有效药物联合应用对PA生物被膜相关感染具有协同作用.磷霉素与抗PA有效药物联合应用对PA感染具有协同或相加作用.近年提出磷霉素与其他抗PA药物联合应用时间差治疗学的方案,系指提前Ih应用磷霉素,可以提高合并用其他药物对PA细胞壁的渗透性,增强疗效.磷霉素与氨基糖苷类药物联合应用可以减轻后者的耳毒性和肾毒性.PK/PD理论的应用:抗PA的青霉素类和头孢菌素类与其与酶抑制剂复合制剂均属于时间依赖性抗生素,T>MIC%与临床疗效密切相关.这类药物需日剂量分3~4次给药,以延长药物与PA的接触时间,加强杀菌作用,提高临床疗效.抗PA碳青霉烯类属于时间依赖性但抗菌后效应持续时间较长的抗生素,可通过延长滴注时间提高对PA严重感染的疗效,如美罗培南、亚胺培南和多尼培南可缓慢持续静脉输注2~3h,目的是延长给药间隔内血药浓度高于MIC的时间.氨基糖苷类药物是浓度依赖性抗生素,Cmax/MIC与细菌去除率和临床有效率密切相关,同时肾小管上皮细胞与耳蜗毛细胞对较高浓度的氨基糖苷类摄取有"饱和〞现象.国外大量文献报道日剂量单次给药可保证疗效,减少耳、肾毒性,遏制细菌耐药性,故临床实施氨基糖苷类药物日剂量单次给药方案来控制感染性疾病.我国制定的"抗菌药物临床应用指导原如此〔2004>〞中也建议氨基糖苷类药物日剂量单次给药,但鉴于我国生产的氨基糖苷类药物药品说明书尚未按照PK/PD特点来修正,临床需要全面斟酌.。

四川大学博士学位论文铜绿假单胞菌噬菌体、QS系统与生物被膜的相关研究姓名:***申请学位级别:博士专业:病原生物学指导教师:***20060401色8h以上)。
显色完后,将膜浸入双蒸水中漂洗lO分钟以终止反应,尼龙膜经干燥后拍照保存。
1.2结果1.2.1PA噬菌体的分离及其滴度测定从污水中分离到一株以PA0315为宿主的噬菌体,在双层LB琼脂平板上形成圆形噬菌斑,24h培养的噬菌斑直径约1~3mm,噬菌斑形成初期完全透亮且边缘清晰(图1.1—1),放置48h以上则在透明噬菌斑中有次生菌落生长,使噬菌斑变得模糊,表现为溶原性噬菌体噬菌斑的特征。
该噬菌体的编号为PPA5。
根据噬菌体计数结果测得该噬菌体的平均滴度为:1.3x1010pfu/ml。
图1.1-1PPA5感染PA0315后在双层平板上形成的噬菌斑Fig1.1—1PlaquesofhostbacterialPA03i5infectedbyPPA51.2.2PPA5的电镜观察经磷钨酸染色后,透射电子显微镜下可见PPA5为典型的复合体对称型噬菌体,其头部直径约为80nm~90nm,无囊膜包裹;尾部非常明显,长度约为130nm~140nm。
宽度为15nm~20nm(图1.1.2)。
根据“国际病毒分类委员会”(InternationalCommitteeonTaxonomyofVriuses,ICTV)对噬菌体的分类标准,PPA5为肌尾噬菌体科的成员。
图1.1-2噬菌体PPA5的透射电子显微镜照片(×50,000)Fig1.1-2TransmissionelectronmicrographsofphagePPA5(X50,000)A.ThephagePPA5:B.ThePPA5infectedtheflagellumofthehostcellsPA03151.2.3噬菌体PPA5的最佳感染复数按照感染复数分别为0.01、O.1、I、10、100的比例混合噬菌体和宿主菌,培养4h后作噬菌体计数,计算得到各管噬菌体滴度分别为:2.5x109、1.3x10m、6.2)(109和5.6x108pfu/ml。

铜绿假单胞菌体外粘附肠上皮细胞对其细胞膜生物特性的影响陈军;夏培元;常山;肖光夏【期刊名称】《第三军医大学学报》【年(卷),期】2003(25)6【摘要】目的探索铜绿假单胞菌粘附肠上皮细胞后细胞膜生物特性的变化规律及可能的机制。
方法采用体外肠上皮细胞培养模型 ,研究绿脓杆菌粘附后对肠上皮细胞活力、细胞膜磷脂酶A2 、细胞内钙、细胞膜磷脂成分、膜流动性的影响。
结果细菌粘附后 3h肠上皮细胞活力明显下降 ,PLA2 活性增高 ,细胞内钙离子浓度增加 ,肠上皮细胞膜荧光偏振度、微粘度和分子排列有序性系数即出现增加 ,膜流动性降低 ,细胞膜磷脂含量降低 ,磷脂酰肌醇 (PI)、磷脂酰胆碱 (PC)含量逐渐降低。
结论绿脓杆菌粘附后肠上皮细胞胞内钙超载所导致的膜PLA2【总页数】3页(P495-497)【关键词】铜绿假单孢菌;粘附;肠上皮细胞膜;膜流动性【作者】陈军;夏培元;常山;肖光夏【作者单位】第三军医大学附属西南医院全军烧伤研究所【正文语种】中文【中图分类】R322.45;R329.2【相关文献】1.青春双歧杆菌抑制铜绿假单胞菌对肠上皮细胞粘附和侵袭作用的研究 [J], 陈军;常山;张雅萍;肖光夏2.铜绿假单胞菌粘附对肠上皮细胞膜生物物理特性的影响 [J], 陈军;唐鏖;常山;肖光夏3.铜绿假单胞菌体外对肠上皮细胞骨架的影响 [J], 陈军;夏培元;常山;吴泽志;肖光夏4.嗜水气单胞菌体外粘附Caco-2细胞对细胞膜生物学特性的影响 [J], 胡彩虹;夏枚生;熊莉;许梓荣5.甲型链球菌与铜绿假单胞菌对白假丝酵母菌生长及粘附影响的体外观察 [J], 赵辉;赵迎超;顾东明;黄庆华;曹雪芹因版权原因,仅展示原文概要,查看原文内容请购买。



铜绿假单胞菌LCT-PA220菌株全基因组序列测定与分析刘超;苏龙翔;方向群;刘长庭【摘要】目的全基因组测序和分析铜绿假单胞菌LCT-PA220菌株,研究空间因素对细菌全基因组的影响,为宇航员的保健奠定基础.方法通过革兰染色鉴定LCT-PA220属性,提取基因DNA、构建文库并上机测序;加工处理原始测序数据后进行基因组组装、注释和分析.结果铜绿假单胞菌LCT-PA220菌株革兰染色阴性,基因组为6.87M,包括5 829个编码序列,平均长度为962 bp,预测到为54个tRNA基因,COG数据库和KEGG数据库比对共注释到22组COG功能和32条KEGG信号通路.结论铜绿假单胞菌LCT-PA220菌株全基因组测序和基因组清楚,为后续对该菌株的研究打下了基础.【期刊名称】《解放军医学院学报》【年(卷),期】2014(035)007【总页数】4页(P738-740,758)【关键词】铜绿假单胞菌;基因组;测序;编码序列【作者】刘超;苏龙翔;方向群;刘长庭【作者单位】解放军总医院南楼呼吸科,北京100853;解放军总医院南楼呼吸科,北京100853;解放军总医院南楼呼吸科,北京100853;解放军总医院南楼呼吸科,北京100853【正文语种】中文【中图分类】R378铜绿假单胞菌,即绿脓杆菌,是一种非发酵革兰阴性杆菌,菌体细长且长短不一[1]。
它存在于土壤、水、皮肤、呼吸道和肠道等,在自然环境中广泛分布,尤其是在潮湿的环境中,可引起人类和动物的疾病,是人类和动物的条件致病菌[2]。
免疫力低下(长期使用激素类药物、免疫抑制剂、实行肿瘤放疗、化疗治疗)、侵入性诊疗操作(气管切开、保留导尿管等)或手术后的病人易受该菌感染,因此其常被认为是医院内感染的重要病原菌之一[3-4]。
随着生物信息学和新一代测序技术的发展,细菌的基因组研究日趋广泛,为快速研究致病菌株的致病和耐药机制提供了有效的手段[5]。
本研究分析了一株铜绿假单胞菌菌株的全基因组测序结果,为更好地了解该菌株的各种生物学特性提供了一定的理论基础。
铜绿假单胞菌噬菌体的分离鉴定及耐噬菌体突变频率测定张克斌;陈志瑾;金晓琳;饶贤才;胡福泉【期刊名称】《微生物学通报》【年(卷),期】2002(029)001【摘要】用铜绿假单胞菌为宿主菌自污水中分离到3株不同的铜绿假单胞菌噬菌体,命名为PaPI、PaP2及PaP3.3者均为DNA双链噬菌体,基因组大小分别约为47kb、34kb及24kb.3株噬菌体原液滴度(pfu)分别为109/mL、1011/mL和1011/mL.PaPI为裂菌性噬菌体,PaP2及PaP3为溶原性噬菌体.电镜观察,3株噬菌体头部均为多面体立体对称颗粒,直径分别约为70nm、55nm和65m.PaPl属肌尾噬菌体科,PaP2和PaP3属短尾噬菌体科.研究中还发现了铜绿假单胞菌的耐噬菌体现象及耐受菌与敏感菌之间的"菌群交替"现象,经测定铜绿假单胞菌耐噬菌体的突变机率在1.4×10-7~7.9×10-7之间.【总页数】6页(P40-45)【作者】张克斌;陈志瑾;金晓琳;饶贤才;胡福泉【作者单位】第三军医大学基础部微生物学教研室,重庆,400038;第三军医大学基础部微生物学教研室,重庆,400038;第三军医大学基础部微生物学教研室,重庆,400038;第三军医大学基础部微生物学教研室,重庆,400038;第三军医大学基础部微生物学教研室,重庆,400038【正文语种】中文【中图分类】Q93-331【相关文献】1.铜绿假单胞菌噬菌体的分离鉴定及其生物学特性的分析 [J], 郑文旭;成伏波;张学英;孙延波;徐德启2.耐碳青霉烯类鲍曼不动杆菌噬菌体的分离鉴定及其生物学特性 [J], 张劼;罗永艾3.植物乳杆菌噬菌体Lpla的分离鉴定及抗噬菌体菌株的筛选 [J], 齐蕊名;乔薪瑗;于美玲;姜艳平;崔文;张希;王丽;徐义刚;唐丽杰;李一经4.耐亚胺培南铜绿假单胞菌噬菌体分离及其生物学特性分析 [J], 胡北;徐敏超;王晶;刘双又;严群;胡俊波;朱旭慧;孙自镛5.铜绿假单胞菌噬菌体PaP3末端酶大亚单位DNA结合能力的测定 [J], 申晓冬;张克斌;李明;周莹冰;蹇锐;胡晓梅;陈志瑾;饶贤才;胡福泉因版权原因,仅展示原文概要,查看原文内容请购买。
第17卷 第4期 医学研究生学报 Vol.17 No.4 2004年4月 Journal of Medical Postgraduates Apr.2004・论 著・铜绿假单胞菌噬菌体PaP2的结构蛋白及其编码基因的研究黄建军, 胡晓梅, 朱军民, 申晓冬, 李 明, 饶贤才, 胡福泉(第三军医大学基础部微生物学教研室,重庆市微生物工程重点实验室,重庆400038)摘要: 目的:确定铜绿假单胞菌噬菌体PaP2结构蛋白的构成及其编码基因。
方法:CsCl 梯度离心纯化噬菌体PaP2颗粒,SDS 2PAGE 电泳,确定结构蛋白条带及其相对分子质量;然后电转印于PVDF 膜上,用Edman 降解法进行N 端测序。
根据所测的N 端氨基酸残基序列在PaP2预测基因编码的蛋白质中检索,从而逆推其编码基因。
结果:SDS 2PA GE 显示PaP2含有10条带,其中1、3、4、5、8、9等6条带的含量足以回收进行N 端测序,测得N 端氨基酸残基分别依次为:Met 2Ile 2G lu 2Leu 2G ly 、Ala 2Ile 2Ser 2Pro 、Ala 2Arg 2Phe 2Ile 2Asp 、Ser 2Val 2Tyr 2Ala 2G ly 、Ala 2Ile 2Ser 2Arg 2Asn 2和Ser 2Phe 2Ser 2Leu 2G ly 。
据此推论出它们的编码基因分别是ORF183********、ORF441926419、ORF16589218322、ORF827429530、OrF157********、ORF756328309。
结论:噬菌体PaP2含有10个结构蛋白,其中6个主要结构蛋白的编码基因分别是orf 24、orf 8、orf 23、orf 12、orf 22、orf 11。
关键词: 铜绿假单胞菌; 噬菌体; 蛋白质N 端测序; 编码基因中图分类号: Q939.48 文献标识码: A 文章编号: 100828199(2004)0420292204ΞThe constituent proteins of Pseudomonas aeruginosa phagePaP 2and their responding coding genesHUAN G Jian 2jun ,HU Xiao 2mei ,ZHU J un 2min ,SHEN Xiao 2dong ,L I Ming ,HU Fu 2quan(Depart ment of M icrobiology ,the Thi rd M ilitary Medical U niversity ,M icrobiologic Core L ab of Chongqi ng ,Chongqi ng 400038,Chi na )Abstract : Objective :To identify the constituent proteins and their responding coding genes in Pseu 2domonas aerugi nosa phage PaP2. Met hods :Phage particles of PaP2were purified with the method of CsCl gradient centrifugation.The phage constituent proteins separated by SDS 2PA GE were trans 2ferred to a PVDF filter ,six major bands were excised from the membrane and were subjected to N 2ter 2minal sequence with Edman degradation method.The coding genes of the six proteins could be identified by comparing their N 2terminal sequences with amino acids sequence of the coding sequences of PaP2genome. Results :PaP2particles are separated to at least eight bands by SDS 2PA GE.The N 2terminal sequences of six proteins are in turn :Met 2Ile 2G lu 2Leu 2G ly ,Ala 2Ile 2Ser 2Pro ,Ala 2Arg 2Phe 2Ile 2Asp ,Ser 2Val 2Tyr 2Ala 2G ly ,Ala 2Ile 2Ser 2Arg 2Asn and Ser 2Phe 2Ser 2Leu 2G ly.Their concluded coding genes are ORF183********,ORF441926419,ORF16589218322,ORF827429530,ORF157********,ORF756328309. Conclusion :There are ten constituent proteins in PaP2particles.Six corresponding coding genes of them are orf 24,orf 8,orf 23,orf 12,orf 22,orf 11res pectively.Their physical and chemical properties are figured out in this study.K ey w ords : Pseudomonas aerugi nosa ; Phage ; N 2terminal sequencing ; Coding gene・292・Ξ收稿日期: 2003211227基金项目: 2000年度重庆市攻关项目(批准号:6458)作者简介: 黄建军(19692),男,四川岳池人,博士研究生,助理研究员,主要从事噬菌体基因组学研究。
第17卷 第4期 医学研究生学报 Vol.17 No.4 2004年4月 Journal of Medical Postgraduates Apr.2004・论 著・铜绿假单胞菌噬菌体PaP2的结构蛋白及其编码基因的研究黄建军, 胡晓梅, 朱军民, 申晓冬, 李 明, 饶贤才, 胡福泉(第三军医大学基础部微生物学教研室,重庆市微生物工程重点实验室,重庆400038)摘要: 目的:确定铜绿假单胞菌噬菌体PaP2结构蛋白的构成及其编码基因。
方法:CsCl 梯度离心纯化噬菌体PaP2颗粒,SDS 2PAGE 电泳,确定结构蛋白条带及其相对分子质量;然后电转印于PVDF 膜上,用Edman 降解法进行N 端测序。
根据所测的N 端氨基酸残基序列在PaP2预测基因编码的蛋白质中检索,从而逆推其编码基因。
结果:SDS 2PA GE 显示PaP2含有10条带,其中1、3、4、5、8、9等6条带的含量足以回收进行N 端测序,测得N 端氨基酸残基分别依次为:Met 2Ile 2G lu 2Leu 2G ly 、Ala 2Ile 2Ser 2Pro 、Ala 2Arg 2Phe 2Ile 2Asp 、Ser 2Val 2Tyr 2Ala 2G ly 、Ala 2Ile 2Ser 2Arg 2Asn 2和Ser 2Phe 2Ser 2Leu 2G ly 。
据此推论出它们的编码基因分别是ORF183********、ORF441926419、ORF16589218322、ORF827429530、OrF157********、ORF756328309。
结论:噬菌体PaP2含有10个结构蛋白,其中6个主要结构蛋白的编码基因分别是orf 24、orf 8、orf 23、orf 12、orf 22、orf 11。
关键词: 铜绿假单胞菌; 噬菌体; 蛋白质N 端测序; 编码基因中图分类号: Q939.48 文献标识码: A 文章编号: 100828199(2004)0420292204ΞThe constituent proteins of Pseudomonas aeruginosa phagePaP 2and their responding coding genesHUAN G Jian 2jun ,HU Xiao 2mei ,ZHU J un 2min ,SHEN Xiao 2dong ,L I Ming ,HU Fu 2quan(Depart ment of M icrobiology ,the Thi rd M ilitary Medical U niversity ,M icrobiologic Core L ab of Chongqi ng ,Chongqi ng 400038,Chi na )Abstract : Objective :To identify the constituent proteins and their responding coding genes in Pseu 2domonas aerugi nosa phage PaP2. Met hods :Phage particles of PaP2were purified with the method of CsCl gradient centrifugation.The phage constituent proteins separated by SDS 2PA GE were trans 2ferred to a PVDF filter ,six major bands were excised from the membrane and were subjected to N 2ter 2minal sequence with Edman degradation method.The coding genes of the six proteins could be identified by comparing their N 2terminal sequences with amino acids sequence of the coding sequences of PaP2genome. Results :PaP2particles are separated to at least eight bands by SDS 2PA GE.The N 2terminal sequences of six proteins are in turn :Met 2Ile 2G lu 2Leu 2G ly ,Ala 2Ile 2Ser 2Pro ,Ala 2Arg 2Phe 2Ile 2Asp ,Ser 2Val 2Tyr 2Ala 2G ly ,Ala 2Ile 2Ser 2Arg 2Asn and Ser 2Phe 2Ser 2Leu 2G ly.Their concluded coding genes are ORF183********,ORF441926419,ORF16589218322,ORF827429530,ORF157********,ORF756328309. Conclusion :There are ten constituent proteins in PaP2particles.Six corresponding coding genes of them are orf 24,orf 8,orf 23,orf 12,orf 22,orf 11res pectively.Their physical and chemical properties are figured out in this study.K ey w ords : Pseudomonas aerugi nosa ; Phage ; N 2terminal sequencing ; Coding gene・292・Ξ收稿日期: 2003211227基金项目: 2000年度重庆市攻关项目(批准号:6458)作者简介: 黄建军(19692),男,四川岳池人,博士研究生,助理研究员,主要从事噬菌体基因组学研究。
通讯作者: 胡福泉(19532),男,四川珙县人,教授,医学博士,主要从事抗微生物感染及噬菌体基因组学研究。
0 引 言 铜绿假单胞菌噬菌体PaP2是我室自行分离的一株溶原性噬菌体,目前已完成其全基因组测序(基因组为43kb的dsDNA)。
经ORF finder搜索表明基因组中具有154个大于100bp的公开阅读框架(open reading frames,ORF),G eneMark分析提示有51个编码序列(coding sequences,CDS)。
这些预测是生物信息学分析软件的分析结果,需要实验证据来证实;反过来,这些预测结果可以为寻找结构蛋白的编码基因提供帮助。
研究表明,不同噬菌体基因组大小不同,其结构蛋白在数量上差别也较大,多者可达40个以上,少的仅有几个,而且结构蛋白的一级序列差别也非常大,甚至同一宿主菌的不同噬菌体也经常没有任何保守的结构蛋白质1~4。
应用BLAST软件(/)分析噬菌体PaP2,没有检索到与现有蛋白同源的结构蛋白质,故无法确定PaP2的结构蛋白及其编码基因。
本研究首先对纯化的噬菌体PaP2颗粒蛋白作N端测序,根据其在51个预测基因编码的蛋白质中检索结果,确定PaP2结构蛋白的编码基因并分析其特性,为深入研究PaP2打下基础。
1 材料和方法1.1 铜绿假单胞菌噬菌体PaP2的纯化 PaP2为本室自行分离鉴定株5。
将PaP2和宿主菌混合液200ml经DNaseⅠ及RNase A消化,除去细菌残渣后,用PEG8000沉淀噬菌体颗粒,用4ml TM液溶解,加在密度分别为1.45g/ml、1.50g/ml、1.70 g/ml的三层CsCl梯度液上,22000r/min离心2h,收集二、三层之间的灰蓝色区带,透析后即得到纯化的PaP2颗粒。
1.2 噬菌体PaP2蛋白的SDS2PA GE 参照《分子克隆实验指南》第二版6,配备12%分离胶和5%积层胶,在PaP2纯化颗粒和中分子量蛋白质标准中分别加入等量2×加样缓冲液,煮沸5min后上样电泳。
30V约40min后换为90V,待溴酚蓝指示剂到达凝胶下缘时,停止电泳。
用考马斯亮蓝R2250染色观察。
1.3 PaP2蛋白转印PVDF膜 参照网站http:// www.expasy.ch/ch2d/protocols/protocols.fm8. html/提供方法。
将平衡好的PVDF膜、Whatman 滤纸和SDS2PA GE后切去积层胶的凝胶制备三明治夹层,由正极到负极依次为:三层Whatman滤纸、PVDF膜、稍小于PVDF膜的凝胶块、稍小于凝胶块的三层Whatman滤纸,4℃恒压30V电转印过夜。
取出PVDF膜染色、脱色。
1.4 蛋白质的N2端测序 剪下PVDF膜上各蛋白质条带送北京大学生命科学院进行N2端测序,使用Edman降解法,在ABM494A蛋白测序仪上完成。
1.5 主要结构蛋白编码框的确定 根据实验测得的N2端氨基酸残基序列,从G enemark所预测的51个基因表达的蛋白质中查询对应的编码框。
1.6 主要结构蛋白质的一般性质分析 通过DNASTAR和网站http://www.expasy.ch/可对这些结构蛋白的相对分子质量(MW)、等电点(p I)和氨基酸组成等进行分析。
2 结 果2.1 噬菌体结构蛋白的SDS2PA GE图谱 SDS2 PA GE结果见图1。
电泳后,在凝胶上可以清晰地看到10条带,按相对分子质量从大到小依次编为1~10号,其中第1、3、4等3条带的含量很大,是主要的结构蛋白。
图1 PaP2噬菌体蛋白SDS2PA GE电泳图谱Figure1 SDS2PA GE of Phage PaP2constituent Proteins(lane1、2)and molecular mass markers(lane M)2.2 噬菌体蛋白转印PVDF膜图谱 噬菌体蛋白先经SDS2PA GE分离,再转印到PVDF膜上,染色后如图2所示。
SDS2PA GE分离产生的蛋白条带,经转印后在PVDF膜上有9条清晰可见,只有凝胶上的第7条带为肉眼不可见。
2.3 主要结构蛋白N2端测序结果 切下转印后PVDF膜上各条蛋白带进行测序。
结果得知,凝胶上的第1、3、4、5、8、9带对应蛋白质N2端氨基酸残基序列分别依次是:Met2Ile2G lu2Leu2G ly(M IqL G)、Ala2Ile2Ser2Pro(A ISP)、Ala2Arg2Phe2Ile2Asp (ARFID)、Ser2Val2Tyr2Ala2G ly(SV YA G)、Ala2Ile2 Ser2Arg2Asn(A ISRN)和Ser2Phe2Ser2Leu2G ly(SF2 SL G)。